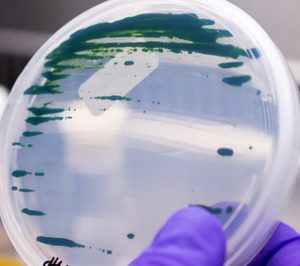
Unilever abre una nueva línea de I+D con la chlorella para potenciar su gama vegetal

Unilever ha sellado una alianza con la "start up" británica Algenuity, especializada en el desarrollo de microalgas para productos de consumo, para explorar nuevas formas de llevar al mercado alimentos elaborados con microalgas, que pasarían a formar parte de la cartera de productos vegetales de la multinacional. A través de esta alianza, Algenuity trabajará en el equipo de I+D+i de Unilever, dentro de la división de 'Food & Refreshments'. "El desarrollo de fuentes alternativas a la proteína animal, como las microalgas, representa un importante paso adelante en el cambio hacia un sistema alimentario equilibrado y respetuoso con el medio ambiente", se afirma desde Unilever. "Las microalgas, continúan, son uno de los ingredientes del futuro, y constituyen una importante alternativa ante la necesidad de impulsar un cambio hacia un sistema alimentario más justo y equitativo, debido al gran impacto para el planeta que genera el consumo de proteína de origen animal".
La propuesta de valor de Algenuity se basa en el desarrollado una tecnología que ha logrado superar las limitaciones organolépticas -color y sabor amargo- de la chlorella, a través de la reducción del contenido de clorofila de esta microalga, reteniendo sus nutrientes naturales. Así, se afirma que esta innovación constituye un potencial enorme en la inclusión de la chlorella en el campo de la alimentación y bebidas, brindando la oportunidad de desarrollar nuevos alimentos proteicos sostenibles que satisfagan la demanda de los consumidores de alimentos nutritivos y con un buen sabor. "Las microalgas son una alternativa a la proteína convencional con mucho potencial aún sin explorar", asegura Xavier Mon, vicepresidente de 'Foods & Refreshment' de Unilever España, "sin duda, jugarán un papel importantísimo en relación a los nuevos modelos de alimentación cada vez más orientados hacia el consumo de productos de origen vegetal; tenemos muchas ganas de trabajar codo con codo con Algenuity para hacer que los alimentos a base de microalgas sean comunes en nuestra dieta".
La chlorella vulgaris es una alga verde, comestible y ampliamente reconocida por expertos como una fuente de proteína vegetal y fibra. Esta alga, con una huella medioambiental muy baja, posee una serie de nutrientes beneficiosos adicionales que incluyen antioxidantes, vitaminas, minerales y ácidos grasos esenciales. A pesar de haberse consumido en todo el mundo durante muchos años, su color verde y sabor amargo debido al alto contenido en clorofila han constituido una barrera para su inclusión en las dietas convencionales.